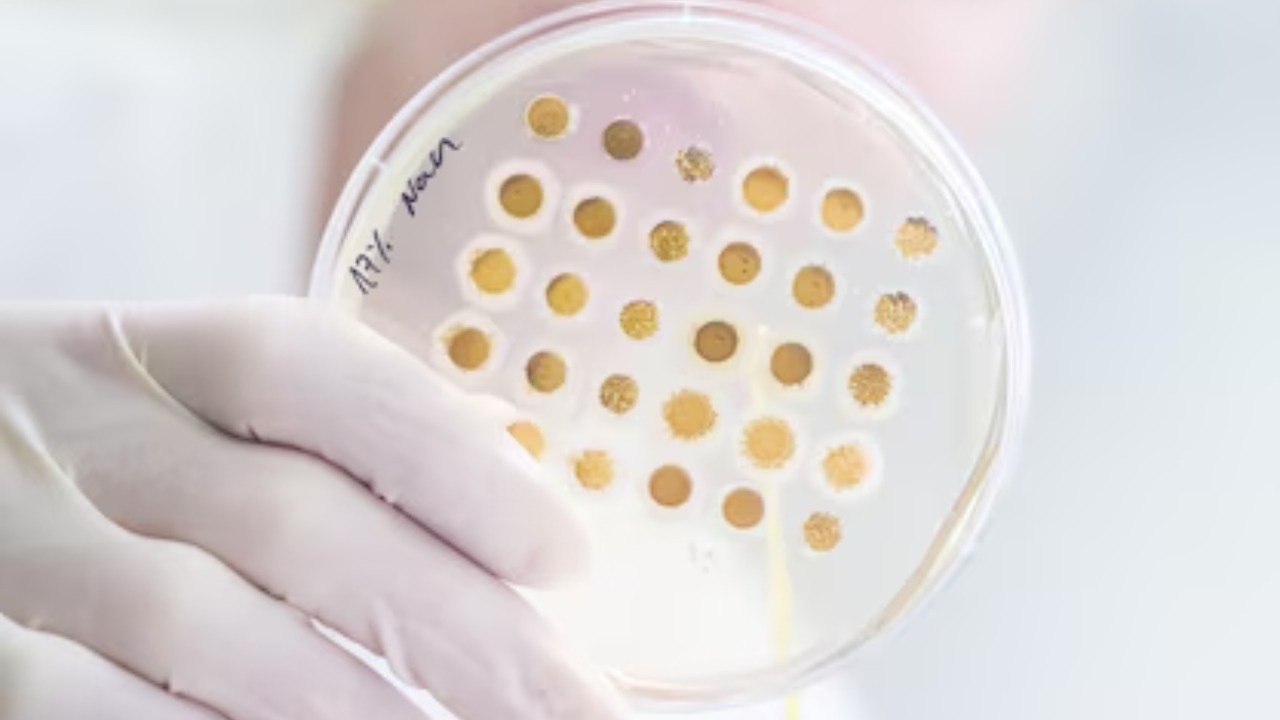
Image by Freepik

The field of regenerative medicine is making significant strides, particularly with the development of bioengineered skin designed to heal burns without leaving scars. This breakthrough has the potential to revolutionize burn treatment and improve patients’ quality of life significantly.
Concept of Bioengineered Skin

Bioengineered skin is a laboratory-grown skin substitute, often developed using a patient’s own cells or other biological materials. This advanced healthcare solution is designed to replicate the natural properties and functions of healthy human skin. It is engineered to promote wound healing, protect against infection, and, in the case of burns, minimize scarring. The science behind bioengineered skin involves complex biological and biochemical processes, including cell culture, tissue engineering, and biotechnology.
The development of bioengineered skin begins with the collection of skin cells from a patient or a donor, which are then cultivated in a controlled laboratory environment. These cells multiply and mature to form skin tissues. The new skin is then carefully grafted onto the patient’s wound or burn area, where it integrates with the existing skin and promotes healing. The aim is not just to close the wound, but also to restore skin’s aesthetic, sensory, and functional characteristics.
The Science of Scar-Free Healing

Scarring is a common and often distressing outcome of burn healing. When skin is injured, the body responds by producing collagen to repair the wound. However, the newly formed skin is often of inferior quality, leading to visible, sometimes disfiguring, scars. The science of scar-free healing involves influencing this process at the cellular level, promoting the formation of skin that closely mimics the original, uninjured skin.
How does bioengineered skin achieve this? It’s all down to the immune cells. Bioengineered skin is designed to influence the behavior of smaller immune cells, known as macrophages. These cells play a critical role in the body’s healing process, and controlling their activity can lead to better, scar-free healing. According to a Stanford Medicine study, smaller macrophages are associated with less scarring compared to their larger counterparts.
Research and Studies on Bioengineered Skin

Several key studies and clinical trials have provided promising evidence for the efficacy of bioengineered skin. Stanford Medicine’s research, already mentioned, is a prominent example. Other significant studies have been published in respected medical journals, demonstrating the positive outcomes of using bioengineered skin for burn treatment.
A study referenced in SAGE Journals pointed towards the potential of a bioengineered dermal-epidermal skin substitute in treating full-thickness burns. Another paper published in the Tissue Engineering journal discussed the successful treatment of severe burns using a bilayered bioengineered skin substitute. These studies and others like them are paving the way for wider adoption of bioengineered skin in clinical settings.
Potential Applications and Benefits
While the immediate application of bioengineered skin is in the treatment of burns, its potential extends far beyond. Bioengineered skin could be used in treating a variety of other skin conditions, such as chronic wounds, ulcers, and skin diseases like vitiligo. It might also play a crucial role in reconstructive surgeries and cosmetic procedures, providing a more natural and aesthetically pleasing outcome.
Scar-free healing has profound benefits, both physical and psychological. Physically, it can restore the function and appearance of the skin, leading to better mobility and sensory perception. Psychologically, it can significantly improve a patient’s self-esteem and quality of life, reducing the emotional trauma often associated with disfiguring scars. A future where the healing of severe burns leaves no trace behind is indeed a promising one.
Challenges and Future Prospects

Despite the remarkable advancements, the development and application of bioengineered skin face several challenges. These include technical difficulties in production, high costs, and regulatory hurdles. Additionally, ensuring the long-term safety and effectiveness of these skin substitutes remains a critical concern.
However, continuous research and technological advancements are expected to overcome these challenges. Future prospects in this field are promising, with researchers aiming to create fully functional skin that not only looks and feels like natural skin but also sweats, grows hair, and responds to touch. The impact of such advancements on healthcare would be transformative, offering new hope to burn victims and those suffering from various skin conditions. As highlighted in a Medical Xpress article, the preclinical success of bioengineered skin is paving the way for its eventual clinical use. The potential of this innovation to change lives is truly exciting.